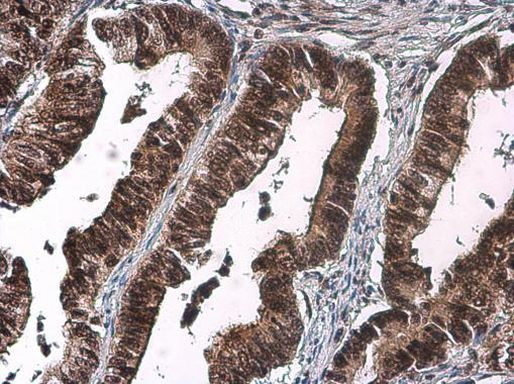
Phospho-CDK2 (Thr160) Antibody in Immunohistochemistry (Paraffin) (IHC (P))

Search
Invitrogen
Phospho-CDK2 (Thr160) Polyclonal Antibody
{{$productOrderCtrl.translations['antibody.pdp.commerceCard.promotion.promotions']}}
{{$productOrderCtrl.translations['antibody.pdp.commerceCard.promotion.viewpromo']}}
{{$productOrderCtrl.translations['antibody.pdp.commerceCard.promotion.promocode']}}: {{promo.promoCode}} {{promo.promoTitle}} {{promo.promoDescription}}. {{$productOrderCtrl.translations['antibody.pdp.commerceCard.promotion.learnmore']}}
产品信息
PA5-77906
种属反应
宿主/亚型
分类
类型
抗原
偶联物
形式
浓度
规格
纯化类型
保存液
内含物
保存条件
运输条件
RRID
产品详细信息
Positive Control: 293T, HeLa, HeLa (10 mM Hydroxyurea treatment for 18 hr)
Predicted Reactivity: Mouse (100%), Rat (100%), Zebrafish (100%), Pig (100%), Chicken (100%), Sheep (100%), Bovine (100%)
Store product as a concentrated solution. Centrifuge briefly prior to opening the vial.
靶标信息
CDK2/cyclinO is a member of the cyclin dependent protein kinase family complexed to CyclinO. CyclinO was used as a specific protein isoform name for the UNG gene which is localized exclusively in the nucleus. In addition, CyclinO was reported to shows significant uracil-DNA glycosylase activity. CDK2/cyclinO protein levels increase during G1 phase and the protein is turned over during the course of cell cycle. The levels of cyclin A-cdk2 is maximal at the G1/S transition and both cdk2 and cyclin A are found associated with DNA in the initiation complex during replication. Rb protein acts as substrate for cdk2-cyclin E and/or cdk2-cyclin A in vivo. Cdk2 is activated and specifically localized to the nucleus during late G1-, S-, and G2-phase.
仅用于科研。不用于诊断过程。未经明确授权不得转售。
篇参考文献 (0)
生物信息学
蛋白别名: cdc2-related protein kinase; CDC28; CDC2A; CDK1; CDK2; Cell division protein kinase 2; Cyclin-dependent kinase 2; EC 2.7.11.22; EC 2.7.11.23; kinase Cdc2; MPF; p33 protein kinase; p33CDK2; p34 protein kinase; unnamed protein product
基因别名: CDK2; CDKN2; p33(CDK2)
UniProt ID: (Human) P24941
Entrez Gene ID: (Human) 1017